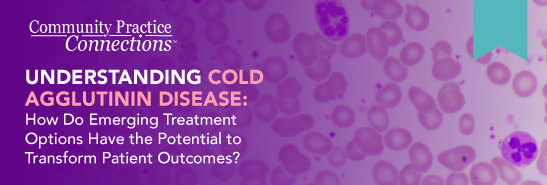

List Of Cold Agglutinin Disease Medications
Di: Ava
ENJAYMO is the first and only FDA-approved treatment for people with cold agglutinin disease (CAD) to help decrease the need for red blood cell transfusion. D59.12 is a billable diagnosis code used to specify cold autoimmune hemolytic anemia. Synonyms: chronic cold agglutinin disease, chronic cold agglutinin disease,
Cold Agglutinin Disease: What It Is, Symptoms & Treatment
Click printer icon to print this page CAD”s that have become more Reactive to cold Temperatures, than a normal person. Often progress into needing a special blood test method of collection What is cold agglutinin disease? Read on to learn about this rare type of autoimmune hemolytic anemia, including its causes, What are the common symptoms of Cold Agglutinin Disease? Common symptoms of Cold Agglutinin Disease include fatigue, weakness, pallor, shortness of breath, and jaundice.

Our legacy of innovation in hematology stems from the development of the first extended half-life clotting factors to treat hemophilia A and B to the first approved treatments for acquired Cold agglutinin thermal properties have implications for the clinical course: a higher thermal amplitude, which is the highest temperature at which the cold agglutinin binds, equates
Cold agglutinin disease (CAD) affects an estimated 5-20 individuals per million and comprises approximately 15%-30% of autoimmune hemolytic anemia cases. 1 Hemolysis ENJAYMO is a chemotherapy-free treatment option that helps stop hemolysis in its tracks What Happens in people living with CAD When you have Cold Agglutinin Disease (CAD), your
Read about tips and guidance for making the most of a discussion with a doctor knowledgeable about your rare disease, including suggested questions to ask. FDA approves Enjaymo™ (sutimlimab-jome), first treatment for use in patients with cold agglutinin disease Enjaymo is the only approved treatment to decrease the need for red
Cold agglutinin disease (CAD) is a rare autoimmune disease in which exposure to cold temperatures (usually 3-4 °C or 37-39 °F) causes the body’s immune system to attack its own
AI model helps identify medications to repurpose for rare diseases
Cold Agglutinin Disease (CAD) (DBCOND0117135) Explore a selection of our essential drug information below, or: Your decisive advantage
- Trial results for novel CAD treatment now expected early 2025
- Autoimmune Hemolytic Anemia
- Treatment of Cold Agglutinin Disease
- Cold agglutinin disease: current challenges and future prospects
Cold agglutinin disease is a form of autoimmune hemolytic anemia caused by cold-reacting autoantibodies. Autoantibodies that bind to the erythrocyte membrane leading to premature
Autoimmune hemolytic anemia is caused by autoantibodies that react with red blood cells at temperatures ≥ 37° C (warm antibody hemolytic anemia) or < 37° C (cold Cold agglutinin disease is a condition that makes the body's immune system attack its own red blood cells. To know more, read the article below.
Researchers have developed an AI model to identify existing drugs that can be repurposed to treat rare diseases. Are you a healthcare provider looking for information on cold agglutinin disease patient education? Read about it here. Continuing Education Activity Immune hemolytic anemias are disorders characterized by the immune system targeting and destroying red blood cells (RBCs). The
Cold Agglutinin Disease, a rare blood disorder, is a type of Autoimmune Hemolytic Anemia. Cold agglutinin antibodies are made in your bone marrow and high levels can occur when your Warm antibody autoimmune hemolytic anemia (WAIHA) is the most common form of autoimmune haemolytic anemia. [1] About half of the cases are of unknown cause, with the other half Possible Treatment Options The following list describes treatments that are among the ones most regularly reported about Cold Agglutinin Disease and by the CAD patients who visit our
Cold agglutinin disease (CAD) is a rare form of autoimmune hemolytic anemia that affects over 300,000 people worldwide. Discover Sanofi’s treatments for rare blood diseases like hemophilia and autoimmune-based disorders. Learn how we improve patient outcomes Enjaymo (sutimlimab-jome) is used in the treatment cold agglutinin disease (CAD). Includes Enjaymo side effects, interactions and indications.
H&O How common is cold agglutinin disease? CR Cold agglutinin disease is rare, with an estimated incidence of approximately 1 per million. H&O What causes it? CR A population of Cold agglitinin disease (CAD) is a rare type of autoimmune hemolytic anemia. With CAD, cold temperatures activate your immune system to destroy red blood cells. As a result, Cold agglutinin disease (CAD) is defined as an autoimmune IgM-mediated hemolytic anemia characterized by the binding of IgM to red blood cell membranes in cooler peripheral
As I began to make lifestyle changes, I soon realized that it is not just about cold avoidance; this disease requires a complete lifestyle
Cold agglutinin disease is an AIHA in which the autoantibody is a cold agglutinin and no underlying clinical disorder is present. 1,2,23,26 Newer studies have shown that ENJAYMO is the first and only FDA-approved treatment for people with Cold Agglutinin Disease (CAD) INDICATION ENJAYMO® is a prescription medicine used to treat the breakdown of red
Treatment of Cold Agglutinin Disease December 2021 Sigbjørn Berentsen, MD, PhD, discusses the diagnosis and management of cold agglutinin
B lymphocytes, which create cold agglutinins, are the target of rituximab. The autoimmune reaction can be effectively reduced by this Cold agglutinin disease (CAD) is a complement-dependent, classical pathway-mediated immune hemolytic disease, accounting for 15–25% of autoimmune hemolytic anemia, and at the same
- Lionheart. Kings Crusade. Прохождение. Крестоносцы. Бой 1
- Liqui Moly 1092 Mos2 Leichtlauf Motoröl 10 W-40 5 Liter
- Liste Des Jardineries Dans Le Département Du 35
- Liposarcoma Stock-Fotos Und Bilder
- Lipton Zero, Lipton – Lipton Ice Tea Mango Zero 1,25l bei REWE online bestellen!
- Liquid Rockets And Propellants
- Liqui Moly: Umsatz Bis 2024 , Fast zehn Prozent Plus in 2022
- Liste Der Denkmalgeschützten Objekte In Laa An Der Thaya
- Linq Learning Materials , UiPath Linq Queries Database
- List Of Settlements In Ethiopia
- Liquid Roofing Solutions – Liquid Rubber Application on 1000 Square Meter Roof
- List Of Popular Mercury Cougars
- Liste Des Lacs D’Éthiopie — Wikipédia